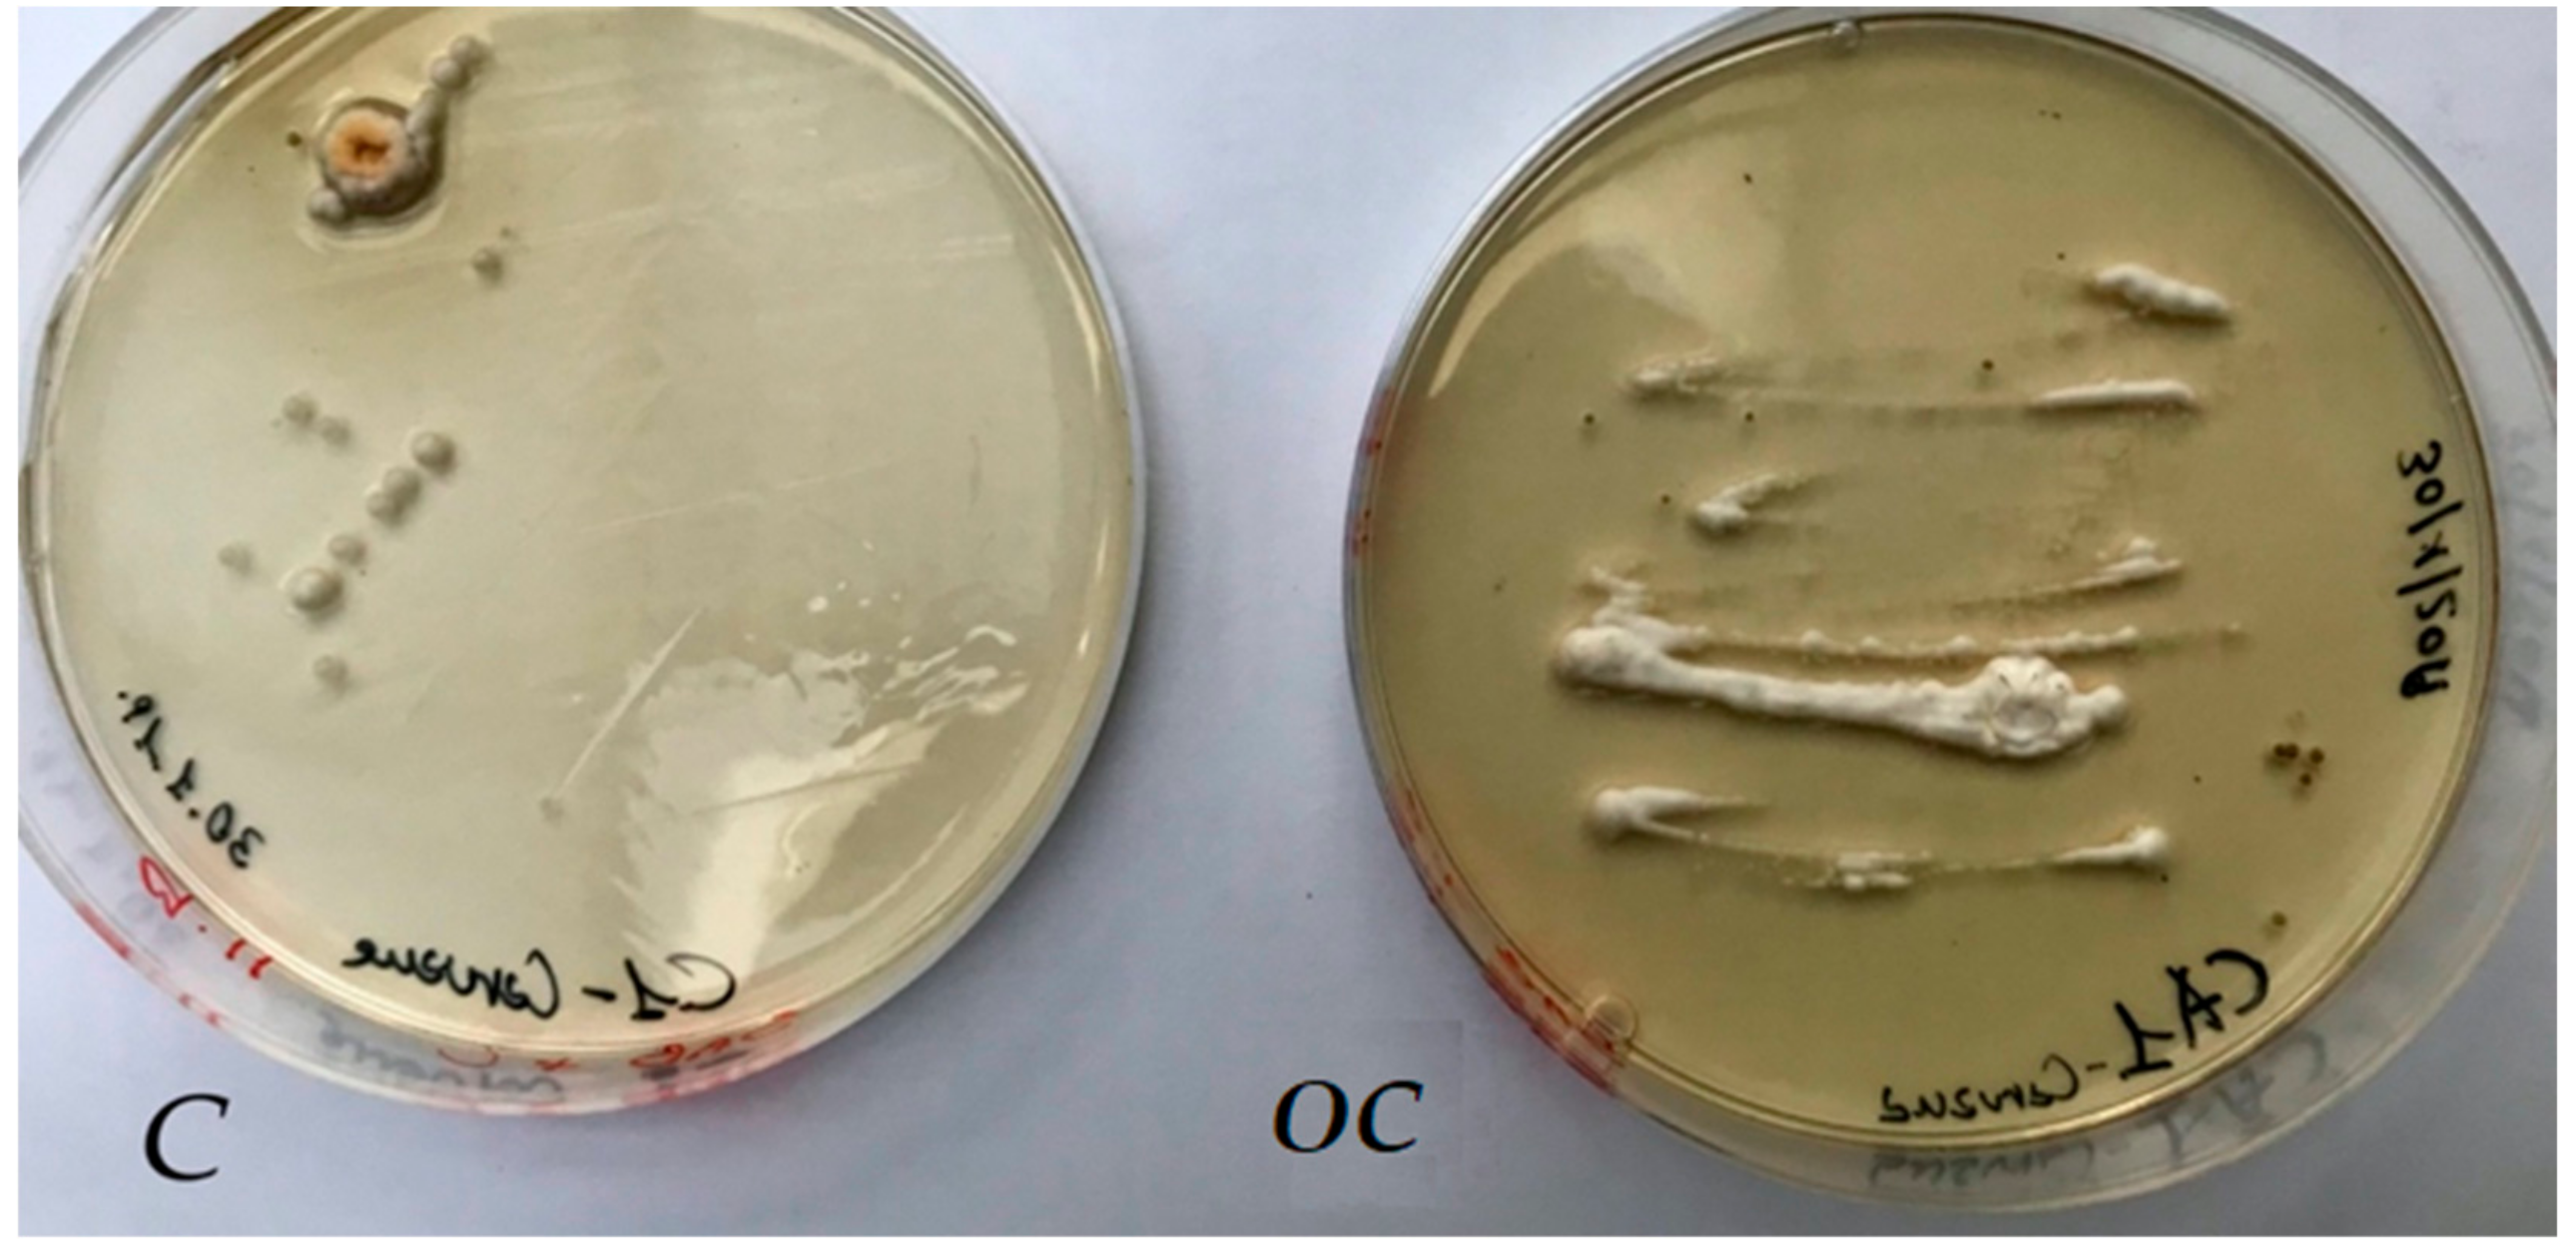
Molecules 25 00730 g006 Molecules 25 00730 g006

Essential Oils as Natural Biocides in Conservation of Cultural Heritage
Abstract
1. Introduction
2. Results
3. Discussion
4. Conclusions
5. Materials and Methods
5.1. Essential Oils (EOs)
5.2. Essential Oil Isolation and Chemical Characterization
5.3. Identification of Compounds
5.4. Pests
5.4.1. Fungal Colonization
5.4.2. Insect Infestation
5.5. Evaluation of Antimicrobial Activity
5.6. EO Volatile Compounds Exposition
Author Contributions
Acknowledgments
Conflicts of Interest
References
- Dakal, T.C.; Cameotra, S.S. Microbially induced deterioration of architectural heritages: Routes and mechanisms involved. Environ. Sci. Eur. 2012, 24, 1–13. [Google Scholar] [CrossRef]
- Di Carlo, E.; Barresi, G.; Palla, F. Biodeterioration. In Biotechnology and Conservation of Cultural Heritage; Springer International Publishing AG: Cham, Switzerland, 2017; pp. 1–30. [Google Scholar]
- Arias-Estévez, M.; López-Periago, E.; Martínez-Carballo, E.; Simal-Gándara, J.; Juan-Mejuto, J.C.; García-Río, L. The mobility and degradation of pesticides in soils and the pollution of groundwater resources. Agric. Ecosyst. Environ. 2008, 123, 247–260. [Google Scholar] [CrossRef]
- Cammarata, M.; Barresi, G.; Palla, F. Biocide. In Biotechnology and Conservation of Cultural Heritage; Springer International Publishing AG: Cham, Switzerland, 2017; pp. 49–65. [Google Scholar]
- Petrovska, B.B. Historical review of medicinal plants usage. Pharmacogn. Rev. 2012, 6, 1–5. [Google Scholar] [CrossRef] [PubMed]
- Nerio Quintana, L.S.; Olivero-Verbel, J.; Stashenko, E. Repellent activity of essential oils from seven aromatic plants grown in Colombia against Sitophilus zeamais Motschulsky (Coleoptera). J. Stored Prod. Res. 2009, 45, 212–214. [Google Scholar] [CrossRef]
- Fernandez-Lopes, J.; Viuda-Martos, M. Application of essential oils in food systems. Foods 2018, 7, 1–4. [Google Scholar]
- Abu-Shanab, B.; Adwan, G.; Abu-Safiya, D.; Jarrar, N.; Adwan, K. Antibacterial Activities of Some Plant Extracts Utilized in Popular Medicine in Palestine. Turk. J. Biol. 2004, 28, 99–102. [Google Scholar]
- Bakkali, F.; Averbeck, S.; Averback, D.; Idaomar, M. Biological effects of essential oils—A review. Food Chem. Toxicol. 2008, 46, 446–475. [Google Scholar] [CrossRef]
- Reichling, J.; Schnitzler, P.; Suschke, U.; Saller, R. Essential oils of aromatic plants with antibacterial, antifungal, antiviral, and cytotoxic properties—An overview. Forsch. Komplementarmed. 2009, 16, 79–90. [Google Scholar] [CrossRef]
- Saad, N.; Muller, C.D.; Lobstein, A. Major bioactivities and mechanism of action of essential oil and their components. Flavour Fragr. J. 2013, 28, 269–279. [Google Scholar] [CrossRef]
- Afifi, H.A.M. Comparative efficacy of some plant extracts against fungal deterioration of stucco ornaments in the Mihrab of Mostafa Pasha, Ribat, Cairo, Egypt. Am. J. Biochem. Mol. Biol. 2012, 2, 40–47. [Google Scholar]
- Salem, M.Z.M.; Zidan, Y.E.; Mansour, M.M.A.; El Hadidi, N.M.N.; Abo Elgat, W.A.A. Antifungal activities of two essential oils used in the treatment of three commercial woods deteriorated by five common mold fungi. Intern. Biodeter. Biodegr. 2016, 106, 88–96. [Google Scholar] [CrossRef]
- Burts, S.A.; Van Der Zee, R.; Koets, A.P. Carvacrol induces heat shock protein 60 and inhibits synthesis of flagellin in Escherichia coli O157: H. Appl. Environ. Microbiol. 2007, 73, 14–15. [Google Scholar] [CrossRef]
- Chorianopoulos, N.G.; Giaouris, E.D.; Skandamis, P.N.; Haroutounian, S.A.; Nychas, G.J.E. Disinfectant test against monoculture and mixed-culture biofilms composed of technological, spoilage and pathogenic bacteria: Bactericidal effect of essential oil and hydrosol of Satureja thymbra and comparison with standard acid- base sanitizers. J. Appl. Microbiol. 2008, 104, 1586–1596. [Google Scholar] [CrossRef]
- Rakotonirainy, M.S.; Lavédrine, B. Screening for antifungal activity of essential oils and related compounds to control the biocontamination in libraries and archives storage areas. Intern. Biodeter. Biodegrad. 2005, 55, 141–147. [Google Scholar] [CrossRef]
- Fierascu, I.; Ion, R.M.; Radu, M.S.O.; Bunghez, I.R.; Avramescu, S.M.; Fierascu, R.C. Comparative study of antifungal effect of natural extracts and essential oils of Ocimum basilicum on selected artefacts. Rev. Roum. Chim. 2014, 59, 207–211. [Google Scholar]
- Casiglia, S.; Bruno, M.; Scandolera, E.; Senatore, F. Influence of harvesting time on composition of the essential oil of Thymus capitatus (L.) Hoffmanns. & Link. growing wild in northern Sicily and its activity on microorganisms affecting historical art crafts. Arabian J. Chem. 2019, 12, 2704–2712. [Google Scholar]
- Rotolo, V.; De Caro, M.L.; Di Carlo, E.; Giordano, A.; Palla, F. Plant extracts as green potential strategies to control the biodeterioration of cultural heritage. Intern. J. Conservat. Sci. 2016, 7, 839–846. [Google Scholar]
- Palla, F.; Barresi, G. Biotechnology and Conservation of Cultural Heritage; Springer International Publishing: Cham, Switzeland, 2017. [Google Scholar]
- Balouiri, M.; Sadiki, M.; Ibnsouda, S.K. Methods for in vitro evaluating antimicrobial activity: A review. J. Pharm. Anal. 2016, 6, 71–79. [Google Scholar] [CrossRef]
- Tripathi, A.K.; Upadhyay, S.; Bhuiyan, M.; Bhattacharya, P.R. A review on prospects of essential oils as biopesticide in insect-pest management. J. Pharmacogn. Phytoter. 2009, 15, 1–12. [Google Scholar]
- Satyal, P.; Murray, B.L.; McFeeters, R.L.; Setzer, W.N. Essential oil characterization of Thymus vulgaris from various geographical locations. Foods 2016, 5, 70. [Google Scholar] [CrossRef]
- Duke, J.A. Handbook of Phytochemical Constituents of GRAS Herbs and Other Economic Plants; CRC Press: Boca Raton, FL, USA, 1992. [Google Scholar]
- Zambonelli, A.; Zechini D’Aulerio, A.; Severi, A.; Benvenuti, S.; Maggi, L.; Bianchi, A. Chemical composition and fungicidal activity of commercial essential oils of Thymus vulgaris L. J. Essent. Oil Res. 2004, 16, 69–74. [Google Scholar] [CrossRef]
- Lukas, B.; Schmiderer, C.; Novak, J. Essential oil diversity of European Origanum vulgare L. (Lamiaceae). Phytochemistry 2015, 119, 32–40. [Google Scholar] [CrossRef] [PubMed]
- Caneva, G.; Nugari, M.P.; Salvadori, O. Plant Biology for Cultural Heritage; Getty Conservation Institute: Los Angeles, CA, USA, 2008. [Google Scholar]
- Boyer, L.; Seifert, S.; Odegaard, N.; Pool, M. Understanding the Hazards: Toxicity and Safety. In Old Poisons, New Problems: A Museum Resource for Managing Contaminated Cultural Materials; AltaMira Press: Walnut Creek, CA, USA, 2005; pp. 73–85. [Google Scholar]
- Marcotte, S.; Estel, L.; Leboucher, S.; Minchin, S. Occurrence of organic biocides in the air and dust at the Natural History Museum of Rouen, France. J. Cult. Herit. 2014, 15, 68–72. [Google Scholar] [CrossRef]
- Guiamet, P.S.; De la Paz, J.N.; Arenas, P.M.; Gómez de Saravia, S.G. Differential sensitivity of Bacillus sp. isolated from archive materials to plant extracts. Pharmacologyonline 2008, 3, 649–658. [Google Scholar]
- Stupar, M.; Grbić, M.L.; Džamić, A.; Unković, N.; Ristić, M.; Jelikić, A.; Vukojević, J. Antifungal activity of selected essential oils and biocide benzalkonium chloride against the fungi isolated from cultural heritage objects. Sout. Afr. J. Bot. 2014, 93, 118–124. [Google Scholar] [CrossRef]
- Sakr, A.A.; Ghaly, M.F.; El-Sayed, F.; Abdel-Haliem, M. The efficacy of specific essential oils on yeasts isolated from the royal tomb paintings at Tanis, Egypt. Int. J. Conserv. Sci. 2012, 3, 87–92. [Google Scholar]
- Borrego, S.; Valdés, O.; Vivar, I.; Lavin, P.; Guiamet, P.; Battistoni, P.; Gómez de Saravia, S.G.; Borges, P. Essential oils of plants as biocides against microorganisms isolated from Cuban and Argentine documentary heritage. Intern. Sch. Res. Netw. ISRN Microbiol. 2012, 2012, 1–7. [Google Scholar] [CrossRef]
- Rotolo, V.; Pasquariello, G.; De Nuntiis, P.; Margagliotta, R.; Palla, F. Can plant save art? Potential use of essential oil for conservation of Cultural Heritage. In Proceedings of the 2nd Conference on Green Conservation of Cultural Heritage, Palermo, Italy, 16–18 November 2017. [Google Scholar]
- De la Paz, J.; Larionova, M.; Maceira, M.A.; Borrego, S.F.; Echevarria, E. Control of Biodeterioration using a fraction isolated from leaves of Ricinus communis Linn. Pharmacologyonline 2006, 3, 462–466. [Google Scholar]
- Ghalem, B.R.; Mohamed, B. Antibacterial activity of leaf essential oils of Eucalyptus globulus and Eucalyptus camaldulensis. Afr. J. Pharm. Pharmacol. 2008, 2, 211–215. [Google Scholar]
- Karakaya, S.; Nehir El, S.; Karagozlu, N.; Sahin, S. Antioxidant and antimicrobial activities of essential oils obtained from Oregano (Origanum vulgare ssp. hirtum) by using different extraction methods. J. Med. Food 2011, 14, 645–652. [Google Scholar]
- Rotolo, V.; De Caro, M.L.; Giordano, A.; Palla, F. Solunto archaeological park in Sicily: Life under tesserae. Fl. Medit. 2018, 28, 233–245. [Google Scholar]
- Elamin, A.; Takatori, K.; Matsuda, Y.; Tsukada, M.; Kirino, F. New insight on fumigation action of essential oil, commercial fungicide and low oxygen microenvironment on museum mold, Alternaria alternata. Biocontrol Sci. 2019, 24, 123–127. [Google Scholar]
- Lavin, P.; Gómez de Saravia, S.; Guiamet, P. Scopulariopsis sp. and Fusarium sp. in the Documentary Heritage: Evaluation of their biodeterioration ability and antifungal effect of two essential oils. Microb. Ecol. 2016, 71, 628–633. [Google Scholar] [CrossRef] [PubMed]
- Soković, M.; Vukojević, J.; Marin, P.; Brkić, D.; Vajs, V.; Griensven, L.D. Chemical composition of essential oils of Thymus and Mentha species and their antifungal activities. Molecules 2009, 14, 238–249. [Google Scholar] [CrossRef]
- Vukojević, J.; Grbić, M.L. Moulds on paintings in Serbian fine art museums. Afr. J. Microbiol Res. 2010, 4, 1453–1456. [Google Scholar]
- Adams, R.P. Identification of Essential Oil Components by Gas Chromatography/Mass Spectroscopy, 4th ed.; Allured Publishing: Carol Stream, IL, USA, 2007. [Google Scholar]
- Riaz, A.; Awan, H.A.; Rasib, K.; Raza, S. Molecular Identification of Aspergillus flavus using Inter Transcribed Spacers (ITS). Biotechnol. J. Internat. 2017, 20, 1–8. [Google Scholar] [CrossRef]
- Altshul, S.F.; Girsh, W.; Miller, W.; Myers, E.W.; Lipman, D.J. Basic local alignment search tool. J. Mol. Biol. 1990, 215, 403–410. [Google Scholar] [CrossRef]
Sample Availability: Samples of the compounds are not available from the authors. |

| Biocide | Conc. (%) | Inhibition Halo (mm) |
|---|---|---|
| Origanum vulgare | 50.0 | 24 |
| 25.0 | 84 | |
| 12.5 | 9 | |
| Thymus vulgaris | 50.0 | 20 |
| 25.0 | 14 | |
| 12.5 | 8 | |
| Ethanol | 70 | <6 |
| Benzalk–Cl | 0.2 | <6 |
| Nipagin M | 0.2 | <6 |
| LRI a | LRI b | Compound | T. vulgaris (%) | O. vulgare (%) | Id c |
|---|---|---|---|---|---|
| 927 | 1028 | α-Pinene | 1.49 | 1.75 | 1, 2, 3 |
| 943 | 1060 | Camphene | 1.03 | - | 1, 2, 3 |
| 992 | 1149 | β-Myrcene | 2.00 | - | 1, 2, 3 |
| 1029 | 1255 | p-Cymene | 11.29 | 18.97 | 1, 2, 3 |
| 1061 | 1248 | γ-Terpinene | 2.52 | 4.50 | 1, 2 |
| 1086 | 1534 | β-Linalool | - | 2.81 | 1, 2, 3 |
| 1195 | 1690 | α-Terpieol | - | 1.34 | 1, 2 |
| 1302 | 2174 | Thymol | 8.25 | 27.18 | 1, 2, 3 |
| 1305 | 2194 | Carvacrol | 64.96 | 4.04 | 1, 2, 3 |
| 1397 | 1579 | β-Caryophyllene | - | 5.89 | 1, 2, 3 |
| 1456 | 1653 | α-Caryophyllene | 1.40 | 3.61 | 1, 2 |
| 1584 | 2020 | Caryophyllene oxide | - | 2.00 | 1, 2, 3 |
© 2020 by the authors. Licensee MDPI, Basel, Switzerland. This article is an open access article distributed under the terms and conditions of the Creative Commons Attribution (CC BY) license (http://creativecommons.org/licenses/by/4.0/).
Share and Cite
Palla, F.; Bruno, M.; Mercurio, F.; Tantillo, A.; Rotolo, V. Essential Oils as Natural Biocides in Conservation of Cultural Heritage. Molecules 2020, 25, 730. https://doi.org/10.3390/molecules25030730
Palla F, Bruno M, Mercurio F, Tantillo A, Rotolo V. Essential Oils as Natural Biocides in Conservation of Cultural Heritage. Molecules. 2020; 25(3):730. https://doi.org/10.3390/molecules25030730
Chicago/Turabian StylePalla, Franco, Maurizio Bruno, Federica Mercurio, Antonella Tantillo, and Valentina Rotolo. 2020. "Essential Oils as Natural Biocides in Conservation of Cultural Heritage" Molecules 25, no. 3: 730. https://doi.org/10.3390/molecules25030730
APA StylePalla, F., Bruno, M., Mercurio, F., Tantillo, A., & Rotolo, V. (2020). Essential Oils as Natural Biocides in Conservation of Cultural Heritage. Molecules, 25(3), 730. https://doi.org/10.3390/molecules25030730
